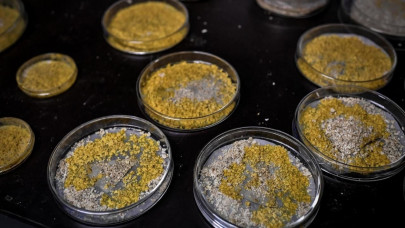

NASA
More News
-
Hubble telescope spots Earendel, the most distant star on record
Hubble Space Telescope just discovered the most distant star on record and have nicknamed it Earendel.
-
NASA confirms 5,000 exoplanets beyond our own solar system
NASA discovers that there are more than 5,000 exoplanets that exist outside of the solar system.
-
NASA to introduce new moon rocket
NASA's next-generation moon rocket began a slow-motion journey out of its launch pad in Florida.
-
Review: ‘Moonfall’ and the death of the 2000s-style disaster flick
Despite being filled with heavy doses of CGI spectacle, the film fails to make an impact
-
Webb telescope spots its first star — and takes a selfie
News comes as a welcome bonus for space fans as NASA previously said ‘a selfie wasn't possible’
-
NASA raises concerns about SpaceX satellite deployment plan
NASA raised concerns about SpaceX's plan to launch 30,000 satellites, fearing its potential impacts on space missions.
-
NASA to launch rocket from Mars for the first time
NASA is on a mission to collect samples from Mars and retrieve them to Earth by launching a rocket from the planet.
-
NASA offers $1 million for systems to feed astronauts
NASA invites the public to come up with an innovative idea to provide nutritional and sustainable food in space
-
Chinese lunar lander discovers water on moon
Chang'E-5 became the first mission to retrieve samples from moon and confirm the presence of water on its surface
-
Second alien moon identified is much like the first: big and strange
Data obtained by indicated the presence of a moon 2.6 times the diameter of Earth orbiting a Jupiter-sized gas giant
-
Next-generation James Webb telescope fully deployed in space
Next steps include aligning the telescope's optics, and calibrating its scientific instruments, according to NASA
-
NASA launches revolutionary space telescope to give glimpse of early universe
‘From a tropical rain forest to the edge of time itself, James Webb begins a voyage back to the birth of the universe’
-
Russia hopeful of space rides from NASA to ISS from 2022
Moscow is expecting NASA to resume the operation of taking their cosmonauts to the International Space Station again.
-
US probe to make unprecedented plunge into sun's atmosphere
NASA aircraft is set to launch next year into the sun's atmosphere to discover the workings of the star.
-
Daughter of pioneering astronaut Alan Shepard set for Blue Origin spaceflight
Alan Shepherd's daughter is ready to embark on Jeff Bezos' Blue Origin rocketship today.
-
NASA launches rocket to study mysterious region in north pole
CREX-2 launched on first December to investigate the Polar cusp in the north and why the air dynamics are different
-
NASA awards $415.6 million for new space hubs
NASA said that it will reward $415.6 million to develop privately-owned and operated commercial space stations.
-
'Razor-sharp precision': Russia hails anti-satellite weapons test
Defence ministry denies allegations by the US, UK and NATO that the test has been dangerous for orbiting spacecraft
-
Russian anti-satellite missile test endangers space station crew: NASA
An anti-satellite missile test Russia conducted generated a debris field in low-Earth orbit
-
Heinz debuts ‘Marz’ ketchup made from tomatoes grown in Mars-like conditions
Research team working on the Heinz Marz will be first to taste the new product on November 10th live on social media
-
High winds delay France's Thomas Pesquet, other ISS astronauts' return to Earth
Crew-3 has also been delayed several times, including by bad weather
-
WATCH: NASA launches first space probe to study Jupiter's Trojan asteroids
largest known Trojan asteroids are believed to measure as much as 225 kilometres in diameter
-
WATCH: British billionaire Branson takes off for high-altitude launch into space
Virgin Galactic plans for two further test flights of the spaceplane in months ahead
-
NASA announces two new missions to Venus
NASA announced plans on Wednesday to launch a pair of missions to Venus between 2028 and 2030 – its first in decades
-
Virgin Galactic moves one step closer to commercial space flights
Billionaire Richard Branson's private spaceship company Virgin Galactic completed its first manned space flight
-
China says Martian rover takes first drive on surface of Red Planet
China this month joined the United States as the only nation to deploy land vehicles on Mars
-
China's rover sends back its first 'selfies' from Mars
The Zhurong rover was carried into the Martian atmosphere in a lander on Saturday
-
NASA's Voyager 1 spacecraft detects the eerie hum of interstellar space
After 44 years of travel, Voyager 1 is the most distant human-made object in space
-
NASA spacecraft starts trip back to Earth after collecting asteroid samples
NASA spacecraft has begun its two-year journey back to Earth
-
German scientist predicted that person named 'Elon' will take humans to Mars
SpaceX won NASA’s $2.9 billion contract to build a spacecraft to bring astronauts to the moon as early as 2024
-
Perseverance rover captures sound of Ingenuity flying on Mars
NASA's Perseverance rover has for the first time captured the low-pitched whirring of Ingenuity helicopter's blades
-
Debris from China space rocket likely to fall in international waters
The environmentally friendly fuel used by the Long March 5B would not pollute the ocean
-
SpaceX Starship rocket prototype achieves first safe landing
Musk has said he intends to fly Japanese billionaire Yusaku Maezawa around the moon with the Starship in 2023
-
Egos clash in Bezos and Musk space race
SpaceX and Blue Origin compete for contracts with US military or space agencies
-
Meet the Palestinian engineer behind helicopter flight on Mars
Loay Elbasyouni, born and raised in Gaza is part of the team that designed NASA’s mini Mars helicopter Ingenuity
-
Four astronauts return from space station aboard SpaceX capsule
Their return marked the end of the first crew rotation mission to the station by the Crew Dragon spacecraft
-
NASA's Mars helicopter Ingenuity shifts into new operational test phase
The next flight will send Ingenuity on a one-way trip to a new 'air field' in two or three weeks
-
Michael Collins the ‘forgotten’ astronaut of Apollo 11 dies at 90
Collins remained alone in the command module for more than 21 hours until his two fellow astronauts returned
-
China launches first module for new space station
This is a milestone in Beijing's ambitious plan to establish a permanent human presence in space
-
French astronaut Thomas Pesquet takes 'blobs' to space
Blobs are strange single-celled organisms that are neither plants nor animals nor funghi
-
NASA's Mars helicopter's third flight goes farther, faster than before
The Perseverance rover, which carried the four-pound rotorcraft to Mars, filmed the 80-second third flight
-
NASA-SpaceX set to launch next 4-member crew to International Space Station
The mission marks the second 'operational' space station team to be launched by NASA
-
A black hole dubbed 'the Unicorn' may be galaxy's smallest one
The researchers said the black hole is roughly three times the mass of our sun
-
In first, Perseverance Mars rover makes oxygen on another planet
The six-wheeled robot has converted some carbon dioxide from the Martian atmosphere into oxygen
-
NASA makes history with first helicopter flight on Mars
NASA's miniature robot helicopter Ingenuity performed a successful takeoff and landing on Mars
-
Three astronauts return from International Space Station
The three had been at the space station since mid-October 2020
-
Musk's SpaceX wins $2.9 billion contract to land humans on moon
NASA awarded SpaceX a $2.9 billion contract to build a spacecraft to bring astronauts to the moon as early as 2024
-
UAE partners with Japan's iSpace to send rover to the moon in 2022
The UAE is using its space programme to develop its scientific and technological capabilities
-
Soyuz crew to blast off and mark 60 years of spaceflight
Soyuz crew will blast off to the International Space Station honoring the 60th anniversary of cosmonaut Yuri Gagarin
-
Telescope reveals thousands of star-forming galaxies in early universe
Telescope has detected stars being born in tens of thousands of distant galaxies with unprecedented precision